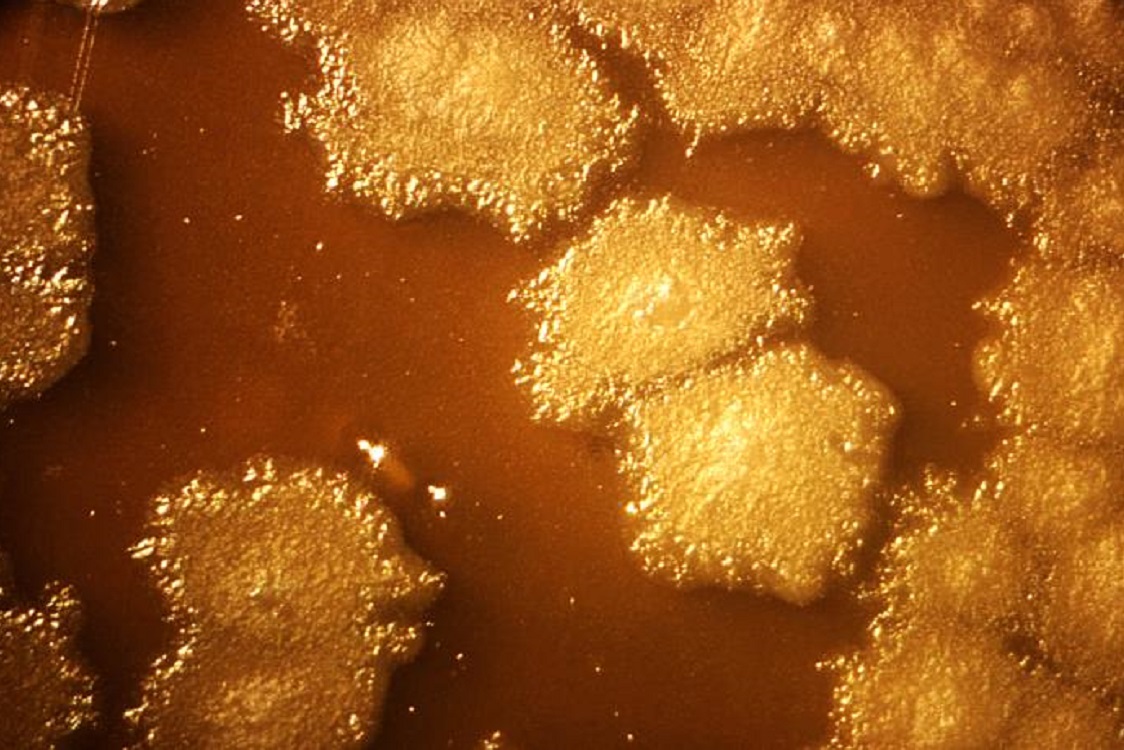

Il batterio mangia-tumori divora masse neoplastiche dall’interno, rivoluzionando la terapia oncologica.
L’impiego di batteri “mangia-tumori” rappresenta una delle innovazioni più promettenti della microbiologia applicata all’oncologia. Attraverso sofisticate modifiche genetiche di biologia sintetica, i ricercatori hanno trasformato comuni microrganismi del suolo in agenti terapeutici capaci di individuare e distruggere selettivamente le masse cancerose.
Questo approccio sfrutta una vulnerabilità specifica dei tumori solidi: la presenza di un nucleo ipossico, ovvero privo di ossigeno, ma estremamente ricco di nutrienti derivanti dalle cellule necrotiche. Attaccando la neoplasia dall’interno, questa strategia punta a massimizzare l’efficacia del trattamento riducendo drasticamente gli effetti collaterali sistemici tipici delle terapie convenzionali.
Clostridium sporogenes: il protagonista della terapia
Il microrganismo al centro di questa ricerca è il Clostridium sporogenes, un batterio anaerobio obbligato presente in natura nel terreno. La sua caratteristica principale è l’incapacità di sopravvivere in presenza di ossigeno, il che lo rende il candidato ideale per colonizzare i nuclei ipossici dei tumori solidi.
Poiché le masse neoplastiche crescono più velocemente dei vasi sanguigni che dovrebbero alimentarle, si creano zone interne prive di ossigenazione. Le spore di Clostridium sporogenes, una volta iniettate, germinano esclusivamente in questi microambienti protetti, iniziando a consumare le risorse cellulari e “divorando” letteralmente la massa tumorale dall’interno verso l’esterno.
Meccanismo d’azione e biologia sintetica
Il processo si attiva quando le spore individuano l’ambiente ideale. Moltiplicandosi, il batterio metabolizza i nutrienti essenziali per le cellule cancerose, inducendo una necrosi progressiva. A differenza della chemioterapia, che colpisce indiscriminatamente tutte le cellule ad alta velocità di divisione, la batterioterapia agisce in modo mirato sulla struttura fisica del tumore.
Per superare i limiti naturali del batterio, gli scienziati hanno utilizzato la biologia sintetica per inserire specifici circuiti genetici:
-
Tolleranza all’ossigeno: è stato inserito un gene che permette al batterio di sopravvivere brevemente anche nelle zone periferiche più ossigenate del tumore, evitando che la terapia si arresti troppo presto.
-
Quorum sensing: questo sistema di segnalazione chimica agisce come un interruttore. I geni terapeutici si attivano solo quando la densità batterica all’interno del tumore è sufficientemente alta, garantendo che il microrganismo rimanga “silente” mentre circola nel flusso sanguigno.
Lo studio dell’Università di Waterloo
Sebbene spesso citata erroneamente come una ricerca di origine belga, questa innovazione nasce in Canada, presso l’Università di Waterloo. Il team, guidato dal ricercatore Bahram Zargar sotto la supervisione di Brian Ingalls e Pu Chen, ha dimostrato come l’integrazione di tolleranza all’ossigeno e controllo tramite quorum sensing permetta una colonizzazione efficace del tumore.
I risultati pubblicati su ACS Synthetic Biology confermano che il batterio modificato non solo sopravvive nel nucleo ipossico, ma riesce a ridurre sensibilmente la massa neoplastica. Come spiegato dai ricercatori, l’uso di modelli matematici applicati all’ingegneria chimica ha permesso di rendere il comportamento del batterio prevedibile e sicuro.
Vantaggi e sfide future
La batterioterapia offre vantaggi strategici unici:
-
Selettività estrema: risparmia i tessuti sani, limitando l’azione alle zone ipossiche.
-
Sinergia terapeutica: può essere combinata con immunoterapia o chemioterapia; indebolendo il tumore, il batterio rende le cellule superstiti più vulnerabili ai farmaci.
-
Accesso a tumori inoperabili: può raggiungere masse difficilmente trattabili chirurgicamente.
Tuttavia, il percorso verso l’applicazione clinica richiede ancora cautela. Le sfide principali riguardano la risposta immunitaria dell’ospite, che potrebbe eliminare i batteri prima che abbiano completato il loro lavoro, e la necessità di garantire una stabilità genetica assoluta del ceppo modificato per evitare tossicità impreviste.
Conclusioni
Il batterio mangia-tumori segna un cambio di paradigma nella lotta contro il cancro. Trasformando un microrganismo del suolo in un “dispositivo biologico intelligente”, la scienza sta aprendo la strada a trattamenti oncologici più precisi e meno invasivi. Se i trial clinici confermeranno i risultati preclinici, il futuro della medicina personalizzata vedrà i batteri non solo come nemici della salute, ma come potenti alleati nella distruzione mirata delle neoplasie.
Milano Post è edito dalla Società Editoriale Nuova Milano Post S.r.l.s , con sede in via Giambellino, 60-20147 Milano.
C.F/P.IVA 9296810964 R.E.A. MI – 2081845